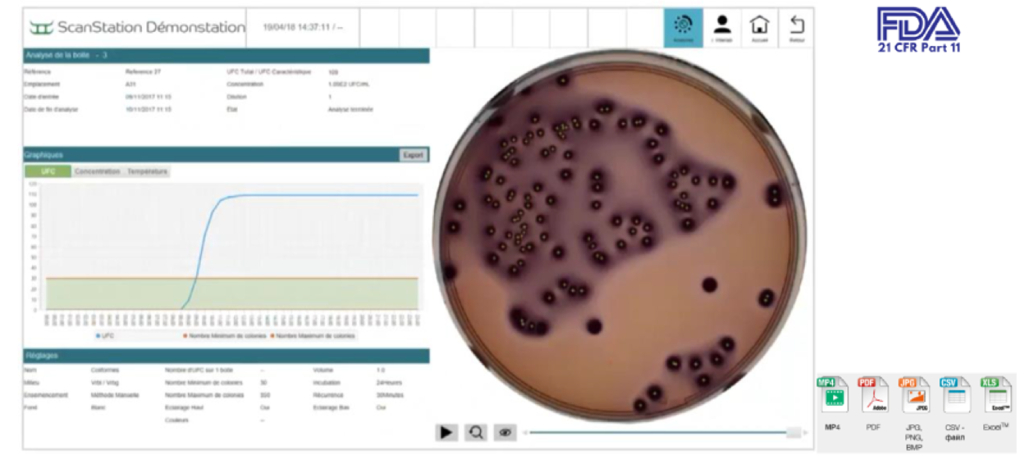

Мы приняли вашу заявку, свяжемся с вами в ближайшее время.

История
Часть товаров из корзины будет перемещена в статус отложенных и не сможет быть оформлена для заказа, если вы продолжите работу в данном регионе
История

История
История

Классический метод подсчета колоний микроорганизмов включает в себя разбавление образца, инкубирование на чашках Петри и подсчет колоний вручную. Такой метод может использоваться для анализа небольшого количества образцов, но в большом потоке ручная работа занимает много времени и увеличивает шанс получения ошибочных результатов вследствие человеческого фактора.
Оперативное получение результатов особенно важно при микробиологическом контроле на производствах, где требуется проводить множество тестов на безопасность продукции, эффективность препаратов или выявление наличия патологических изменений или отклонений от нормы. Поэтому с развитием технологий в науке и медицине появились автоматические и полуавтоматические счетчики колоний, позволяющие значительно ускорить и упростить получение результатов. Среди них особенно выделяется автоматическая система ScanStation.
Станция ScanStation – это роботизированная станция, разработанная для автоматизации инкубации и подсчета колоний на питательных средах в чашках Петри в биологических и микробиологических исследованиях. Даная станция является полностью автоматизированной, что значительно упрощает и ускоряет процессы, связанные с обнаружением и подсчетом микробных колоний.
Станция позволяет получать результаты микробиологического посева намного быстрее, чем при ручных методах микробиологического анализа. В частности, возможен результат подсчета колоний всего за 8 ч, когда колонии слишком малы, чтобы их увидеть невооруженным глазом, но прибор без проблем распознает их.
Производителем ScanStation является французская компания Interscience, которая уже более 40 лет разрабатывает первоклассное оборудование для микробиологии.
| Принцип работы станции |
| Преимущества системы ScanStation |
| Области применения ScanStation |
| Характеристики ScanStation 100 и 200 |
| Автоматизация лаборатории: от подготовки образца до подсчета колоний |
Принцип работы ScanStation основан на сочетании инкубации и автоматизированного подсчета колоний в реальном времени.
ScanStation состоит из инкубатора с каруселью для хранения, роботизированного устройства и автоматического счетчика клеток. Для начала работы оператору необходимо загрузить чашки Петри в инкубаторный модуль, вмещающий до 200 чашек Петри, где создаются оптимальные условия для роста микроорганизмов. Загрузка чашек Петри также может проводиться и во время инкубации.
ScanStation – роботизированный инкубатор и счетчик колоний в реальном времени
После инкубации ScanStation переходит к подсчету колоний в реальном времени, что обеспечивается камерой с высоким разрешением и специальным программным обеспечением, предназначенным для определения и подсчета колоний микроорганизмов на чашках Петри в автоматическом режиме. Программное обеспечение записывает видео роста микроорганизмов в реальном времени и адаптирована ко всем видам чашек Петри и планшетам, а счетчик подсчитывает их количество, отделяя их скопления при чрезмерном росте и артефакты среды.

Идеальное решение, объединяющее классический метод и экспресс-анализ
Полученные результаты подсчета колоний могут быть выведены на экран станции и экспортированы в электронном формате для последующего анализа и отчета.
Представление результатов ScanStation
Программное обеспечение прибора полностью соответствует нормам FDA, что обеспечивает высокий уровень безопасности благодаря возможности использования электронных подписей, зашифрованных данных и контрольных журналов. При работе с ScanStation вы можете назначать различные права пользователей и их уровни доступа.
Особенностью ScanStation является встроенный сканер для почти всех видов одно- и двумерных штрих-кодов, в том числе QR-коды и матрицы данных.
ScanStation также обладает полной совместимостью с другими устройствами Interscience и системой Data Link, тем самым помогает избежать повторного ввода данных, которое может привести к ошибкам, и значительно сэкономить ваше время.
Основные преимущества ScanStation перед другими методами подсчета колоний:
1. Высокая скорость работы. ScanStation способна обработать до 100 чашек Петри менее чем за 30 минут, сокращая время работы и повышая эффективность микробиологической лаборатории в 4 раза.
2. Точность и надежность. Благодаря использованию 5-мегапиксельной камеры Ultra-HD с покадровой съемкой микроорганизмов, станция ScanStation дает высокую точность подсчета колоний, исключая человеческий фактор.
3. Автоматизация процесса. ScanStation полностью автоматизирует процесс подсчета колоний. Ее можно интегрировать с другими системами лаборатории, что делает использование системы еще более удобным и эффективным.
4. Сохранение результатов. Система ScanStation автоматически сохраняет результаты подсчета колоний микроорганизмов. Это упрощает отчетность и архивирование данных и делает их доступными для дальнейшего анализа.
1. Косметическая, фармацевтическая промышленности – сканирование и анализ образцов препаратов, контроль качества, определение концентрации лекарственных веществ и контроль процесса производства.
Пример использования ScanStation на косметическом производстве
2. Медицина – использование при работе с образцами биологических тканей, кровью, мочой или слюной, для диагностики заболеваний, мониторинга состояния пациентов и определения эффективности лекарственных препаратов.
3. Биологические исследования – для исследований в области молекулярной биологии, генетики, протеомики и других смежных областей, например, для изучения взаимодействия белков или определения концентрации нуклеиновых кислот (РНК и ДНК) в пробах.
4. Анализ пищевых продуктов – контроль качества и безопасности пищевых продуктов, идентификации состава и регулирование процессов производства.
ScanStation в пищевой промышленности, Interscience, статья, англ., 4 стр., 2022 г.
5. Экологические исследования – анализ почвы, воды и воздуха, идентификации загрязнителей и оценки состояния окружающей среды.
Применение ScanStation может быть расширено и адаптировано к конкретным потребностям и требованиям отрасли и исследования.

|

|
|
Станция автоматического инкубирования ScanStation 100, Interscience |
Станция автоматического инкубирования ScanStation 200, Interscience |
Для автоматизации, ускорения и облегчения работы микробиологов до непосредственного подсчета колоний производитель Interscience предлагает следующие решения:
Автоматизация микробиологической лаборатории, Interscience, англ., 2023 г.
|
439100
|
|
|
|
По запросу По запросу |
|
|
|
|||||
|
ScanStation — полностью автоматизированная роботизированная система инкубации, детекции и подсчета колоний на питательном агаре в пластиковых чашках Петри d 90 или 55 мм в реальном времени. Полный цикл анализа системой ScanStation в реальном времени включает в себя инкубацию в термостатируемом шкафу на 100 или 200 чашек в зависимости от модели. В период инкубации каждые 30 минут роботизированное устройство переносит чашку в зону счетчика колоний с камерой высокого разрешения для детекции роста и подсчета колоний микроорганизмов на раннем этапе их развития. Система ScanStation сокращает время получения результатов о количестве колоний микроорганизмов в 3 раза по сравнению со стандартным методом проведения микробиологического анализа. Например, результаты можно получить за 8 часов вместо 24 часов при использовании стандартного метода подсчета: в это время колонии микроорганизмов настолько малы, что сложно уловимы невооруженным глазом человека, но легко распознаются камерой. Характеристики инкубатора и счетчика колоний в реальном времени, системы ScanStation 100, Interscience
|
||||||||||||
|
439200
|
|
|
|
По запросу По запросу |
|
|
|
|||||
|
ScanStation — полностью автоматизированная роботизированная система инкубации, детекции и подсчета колоний на питательном агаре в пластиковых чашках Петри d 90 или 55 мм в реальном времени. Полный цикл анализа системой ScanStation в реальном времени включает в себя инкубацию в термостатируемом шкафу на 100 или 200 чашек в зависимости от модели. В период инкубации каждые 30 минут роботизированное устройство переносит чашку в зону счетчика колоний с камерой высокого разрешения для детекции роста и подсчета колоний микроорганизмов на раннем этапе их развития. Система ScanStation сокращает время получения результатов о количестве колоний микроорганизмов в 3 раза по сравнению со стандартным методом проведения микробиологического анализа. Например, результаты можно получить за 8 часов вместо 24 часов при использовании стандартного метода подсчета: в это время колонии микроорганизмов настолько малы, что сложно уловимы невооруженным глазом человека, но легко распознаются камерой. Характеристики инкубатора и счетчика колоний в реальном времени, системы ScanStation 200, Interscience
|
||||||||||||
|
|
||||||||||||
См. также:
Оборудование, приборы:
Автоклавы (стерилизаторы паровые)
Боксы (шкафы) биологической безопасности
Гомогенизаторы лопаточные ("стомакер")
Дилютеры микробиологические, спиральный посев
Маркировка: принтеры, сканеры штрих и 2D-кодов, этикетки
Микробиологические анализаторы
Микробиологический контроль жидкостей, фильтрующие коллекторы (гребенки), пробоотборники
Средоварки и разливочные станции
Счетчики колоний микроорганизмов
Стерилизаторы электрические
Термостаты (инкубаторы) нагревающие
Термостаты (инкубаторы) нагрев и охлаждение
Шкафы сухожаровые (сушильные)
Пластик, стекло, принадлежности:
Мембраны для микробиологического контроля жидкостей
Микробиологические среды, компоненты, добавки
Пеналы для пипеток и чашек Петри
Петли, иглы, шпатели микробиологические
Пипетки мерные, серологические, аспирационные, для переноса (Пастера), пипетки Мора (аликвотные)
Чашки Петри
Штативы для чашек Петри
С помощью личного кабинета Вы сможете:
Сравнение